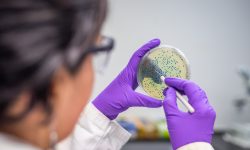
Joburi de viitor: (73) Terraforming Microbiologist

Health Shaperprevine o mulțime de boli prin elaborarea de soluții de sănătate individualizate, cu scopul de a reduce bolile în comunitate, având în vedere îmbătrânirea populației.
Health Shaper: Responsabilități
Health Shapers lucrează cu clienții pentru a propune soluții de sănătate personalizate pentru ei.
Pentru a face acest lucru, ei folosesc o tehnologie care stabilește profilul genetic al clienților, încorporând date de sănătate anterioare, folosind monitorizarea mediului și urmărirea comportamentală constantă.
Asistat de machine learning și big data instrumente Health Shaper identifică și dezvoltă soluții de wellness personalizate pentru clienții lor. Nutriție, exerciții fizice și
intervențiile terapeutice sunt planificate pe bază analizelor și interpretarea de date.
Health Shaper: Abilități
Un Health Shaper vede corpul uman ca un sistem integrat complex. Ei ascultă nevoile clienților și comunică clar, astfel încât soluțiile de îngrijire a sănătății să fie înțelese și urmate corect. Au abilități avansate de utilizare a tehnoligiei, precum și capacități de analiză. De asemenea, vor avea nevoie de cunoștinte despre soluțiile de sănătate și wellnes.